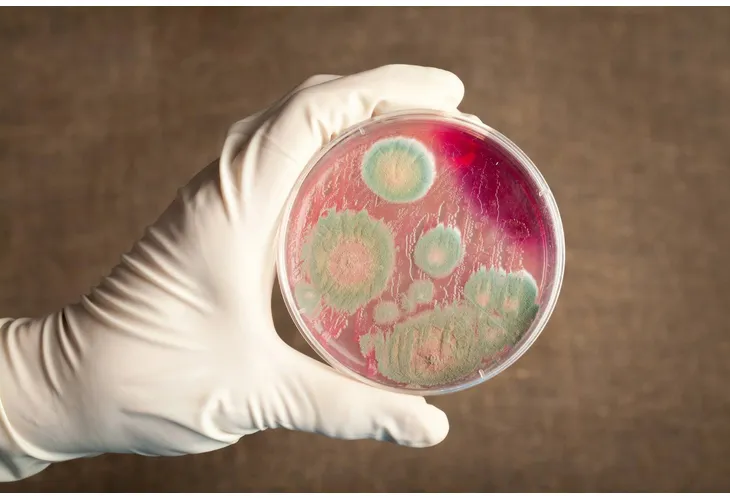
Антракс
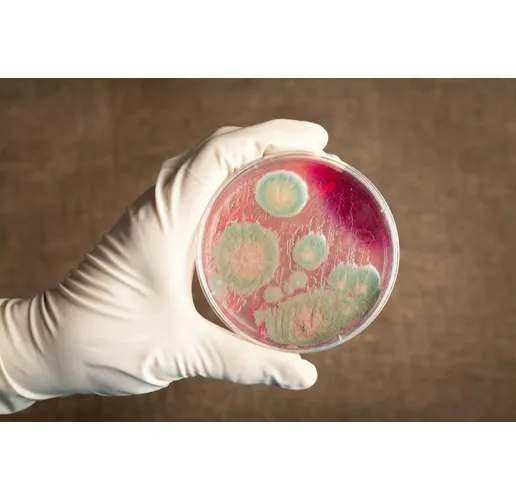
Антракс

Във връзка с огнището на болестта в силистренското село Черногор, РЗИ-Силистра е предприело активно издирване на всички лица, осъществили контакт със заболели животни или консумирали заразена храна.
Към момента са проучени 24 лица, които са насочени към личните лекари за провеждане на антибиотична профилактика и медицинско наблюдение.
Министерство на здравеопазването апелира гражданите да не консумират месо, месни продукти и мляко, които не са закупени от търговската мрежа и не са правилно термично обработени.
При съмнение за консумация на месо или месни продукти със съмнителен произход в суров вид или недобре термично обработени, както и последваща поява на оплаквания от храносмилателната система, е необходимо незабавно да се потърси лекарска помощ, като информирате медицинските лица за вероятността от заболяване от антракс. При съмнение за контакт със замърсени повърхности и предмети и поява на кожни оплаквания също е необходима консултация с лекар.
Антракс е лечимо бактериално заболяване, което протича с различни клинични прояви, в зависимост от начина на заразяване и причинителя – вдишване на прах; контакт с болни животни или замърсени повърхности и предмети; консумация на недостатъчно добре термично обработени заразено месо или месни продукти.
При консумация на заразено месо, вероятността от заразяване с антракс се определя от това дали е проведена термична обработка на дадената храна. При термично обработена храна, се приема, че рискът е много малък. Чревната форма на антракс може да протече с оплаквания като гадене, повръщане, болки в корема и кървава диария.
Навременното провеждане на антибиотично лечение има съществено значение. Всяко лице, консумирало съмнителна храна следва да се обърне към своя общопрактикуващ лекар или към инфекционист за преглед и назначаване на антибиотична профилактика.

%20(2).JPG?s=352016)






.jpeg?s=206570)


.JPG?s=144957)
.JPG?s=130673)



.JPG?s=144957)


.JPG?s=130673)

.JPG?s=149896)





.jpg?s=98167)


.webp?s=87539)
.JPG?s=203721)

.JPG?s=442533)


















.JPG?s=203721)

.JPG?s=442533)



